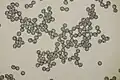
Sporen

Purperrode russula
| Purperrode russula | |||||||||||||||
|---|---|---|---|---|---|---|---|---|---|---|---|---|---|---|---|
| Taxonomische indeling | |||||||||||||||
| |||||||||||||||
| Soort | |||||||||||||||
| Russula queletii Fr. (1872) | |||||||||||||||
| Synoniemen | |||||||||||||||
|
Russula sardonia f. queletii | |||||||||||||||
| Afbeeldingen op | |||||||||||||||
| |||||||||||||||
De purperrode russula (Russula queletii) is een paddenstoel behorend tot het geslacht Russula. Hij komt voor in groepen. Hij is Mycorrhiza vormend met naaldbomen op kalkrijke bodem.
Kenmerken
- Hoed
De hoed heeft een diameter van 4 tot 7 cm, maar kan oplopen tot 10 cm. In het begin is de hoed halfbolvormig en wordt later convex, soms licht ingedrukt met of zonder een lage umbo. De hoedrand is eerst naar binnen gebogen en wordt later recht tot licht naar buiten gebogen, met een geribbelde rand. Het oppervlak is kaal, enigszins plakkerig als het vochtig is. Bij veroudering of blootstelling aan weer verandert het naar bleke en roze gebieden. De hoedhuid is tot de helft aftrekbaar vanaf de rand. De hoed is meestal paarsroze tot dof wijnrood van kleur, maar kan ook paarsbruin van kleur zijn en zelfs olijftinten hebben. Naarmate de hoed ouder wordt en veel water wordt gegeven, vervaagt de hoed aanzienlijk en wordt vervolgens geelachtig groen of roze-grijs.
- Lamellen
De lamellen zijn aangehecht, soms vergroeid, tot subaflopend, dicht op elkaar en relatief breed (5-10 mm). De lamellen zijn op jonge leeftijd witachtig en later crèmekleurig; bij verwonding kunnen ze ook een licht vuile groenachtige kleur krijgen. De lamellen zijn ofwel helemaal niet gevorkt, ofwel alleen direct op de steel gevorkt.
- Steel
De steel is 20-70 (80) × 15-25 mm, recht, rond, massief, bros, gelijkmatig tot licht verdikt aan de onderkant. Het oppervlak is bij de bovenkant bedekt met een poederachtige substantie, elders licht gerimpeld. De kleur varieert, soms volledig roze-wijnkleurig of wit met roze-wijnkleurige blosjes, en de basis is soms geelachtig-beige. Het vlees is wit en verandert niet van kleur, en er is geen partiële sluier. De consistentie van de steel is vrij zacht en meestal een beetje sponsachtig naarmate hij ouder wordt.
- Geur en smaak
Het heeft een vage geur en een zwak tot matig scherpe smaak.
- Sporenprint
De sporenprint is crèmekleurig (IIc-IId volgens Romagnesi).
- Chemische reacties
Het vruchtvlees wordt roodachtig met ijzersulfaat en reageert ook binnen 2 tot 3 minuten met guaiac.
Microscopische kenmerken
De sporen zijn min of meer bolvormig (8–10 × 7–9 µm) en bedekt met bijna puntige wratten tot 1 (1,5) µm hoog. De wratten zijn geïsoleerd en niet als een netwerk met elkaar verbonden. Tussen de wratten mogen alleen fijne lijntjes aanwezig zijn. De basidia zijn 50–60 × 8,5–11(–15) µm groot en hebben vier sterigmata van 4–5 µm breed. De cystiden zijn 51-75 µm lang en 10-11 µm breed, bolvormig of cilindrisch knotsvormig, naar boven gericht, zelden enigszins afgestompt. Oude cystiden worden 100/17 μm groot. In sulfovanilline worden de cystiden bijna geheel blauw. De apiculus meet 1,25 × 1 µm, de duidelijk amyloïde en wratachtige hilarische vlek is onregelmatig en ongeveer 3,25 µm lang en 2 µm breed.
De 5–8 (10) µm brede, min of meer cilindrische tot knotsvormige of bijna nodulaire pileocystidia zijn langwerpig en vaak appendiculair. Sommige pileocystidia zijn 1-2 septaat. De eindcellen van hyfen zijn behoorlijk variabel, ongeveer 2 à 5 µm breed en meer of bolvormig of speenvormig.
Ecologie
Net als de andere russula's is het een mycorrhiza-schimmel die meestal een symbiose vormt met sparren (Picea) en zeldzamer met andere naaldbomen zoals lork (Larix), zilverspar (Abies) en grove den (Pinus sylvestris). De soort wordt van juli tot oktober meestal bij sparren aangetroffen, vaak op nattere plaatsen in het mos. Deze russula geeft de voorkeur aan kalkrijke bodems en bergachtige gebieden; hij is zeldzaam in laaglanden.
Verspreiding

De purperrode russula is een Holarctische soort met een meridionaal tot boreaal verspreidingsgebied. Deze russula komt voor in Noord-Azië (Kaukasus, Oost-Siberië, Rusland-Verre Oosten), Noord-Amerika (VS, Mexico), Noord-Afrika en Europa. In Europa is het wijdverspreid in het zuiden van Portugal tot Roemenië, in het westen van Frankrijk via de Benelux-landen en Groot-Brittannië tot aan de Hebriden en in het oosten tot Wit-Rusland. In het noorden komt het voor in heel Fennoscandinavië. De noordelijke grens van zijn verspreidingsgebied ligt in Lapland.
In Nederland komt de purperrode russula vrij zeldzaam voor. Hij staat op de rode lijst in de categorie 'Kwetsbaar'.
Eetbaarheid
Het is een oneetbare russula. Het eten van deze paddenstoel veroorzaakt buikpijn.
Foto's
-
Sporen
Sporen -

-
